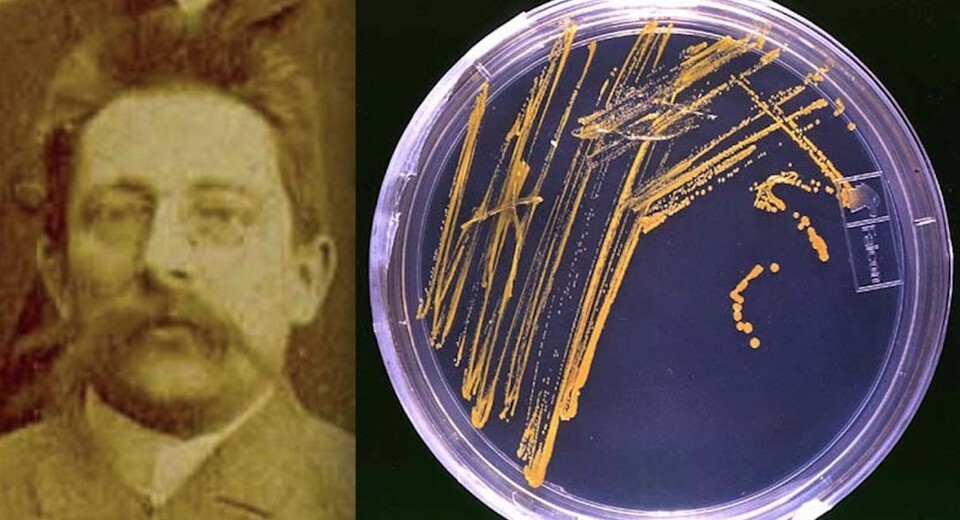
۲۹ آذر در دنیای علم چه خبر؟ ۲۹ آذر در دنیای علم چه خبر؟

۳۰ آذر در دنیای علم چه خبر؟
دنبالهدار جاکوبینی-زینر
۲۰ دسامبر ۱۹۰۰ میلادی برابر با 30 آذر ۱۲۷۹ خورشیدی، میشل جاکوبینی در فرانسه دنبالهداری را کشف کرد که یک آلمانی به نام ارنست زینر هم در ۲۳ اکتبر ۱۹۱۳ آن را بار دیگر کشف کرد و از آن به بعد دنبالهدار جاکوبینی-زینر نام گرفت. این دنبالهدار که هر ۶ و دو/سوم سال یکبار به اطراف زمین باز میگردد، اولین دنبالهداری بود که یک فضاپیما از آن بازدید کرد. در ۱۱ سپتامبر ۱۹۸۵، کاوشگر بینالمللی دنبالهدار (ICE) با سرعت ۲۱ کیلومتر بر ثانیه از دم گازی این دنبالهدار در فاصله ۷هزارو۸۰۰ کیلومتری پایین هسته عبور کرد. هسته در پهنترین قطرش ۲.۵ کیلومتر تخمین زده شد. ابزارهای این فضاپیما مولکولهای مونوسولفیدکربن و مولکولهای هیدروکسیل را در دنبالهدار شناسایی کردند. جاکوبینی-زینر مولد بارش شهابی اژدهایی است که سالانه اوایل اکتبر قابل مشاهده است و در سالهای ۱۹۳۳ و ۱۹۴۶ نمایشهای شهابی شدیدی ایجاد کرد.

لامپ رشتهای
۲۰ دسامبر ۱۸۷۹ میلادی برابر با 30 آذر ۱۲۵۸ خورشیدی، توماس ادیسون، در جلسهای خصوصی لامپ رشتهای اختراعی خود را در پارک منلو در نیوجرسی رونمایی کرد. ادیسون این لامپ را در ۲۱ اکتبر ۱۸۷۹ پساز ۱۳ ماه آزمایش برای کشف ماده مناسب رشته اختراع کرد. او دریافت که رشتههای پنبه کربنیزه میتوانند به مدت ۴۰ ساعت در خلاء داخل یک لامپ شیشهای کار کنند. بعد از نمایش خصوصی، اولین نمایش عمومی این لامپ در پارک منلو در ۳۱ دسامبر ۱۸۷۹ برگزار شد و برای این نمایش، شرکت راهآهن پنسیلوانیا قطارهای ویژهای را به آن مسیر برد تا مردم بتوانند روشناییها را مشاهده کنند.

برق هستهای
۲۰ دسامبر ۱۹۵۱ میلادی برابر با 30 آذر ۱۳۳۰ خورشیدی، در ساعت ۱:۵۰ بعدازظهر، اولین الکتریسیته تولیدشده با نیروی اتمی از ژنراتور توربین ایبیآر-۱ (راکتور آزمایشی ۱) معروف به شمع شیکاگو۴ جریان یافت و توانست برق کافی برای روشنکردن چهار لامپ ۲۰۰ واتی را تولید کند و اینگونه، به اولین نیروگاه هستهای تولیدکننده برق در جهان تبدیل شد. در پی این موفقیت، ایبیآر-۱ برق کافی برای تامین انرژی ساختمان خود را تولید کرد و تا سال ۱۹۶۴همچنان مورد استفاده قرار گرفت و در این سال از رده خارج شد. امروز این راکتور به موزه تبدیل شده و از اواخر ماه مه تا اوایل سپتامبر برای بازدیدکنندگان باز است.

پدر جراحی نوین
۲۰ دسامبر ۱۵۹۰ میلادی برابر با 30 آذر ۹۶۹ خورشیدی، آمبرویز پَره، پزشک و جراح فرانسوی و یکی از بزرگترین جراحان عصر نوزایی اروپا در گذشت. پَره را بهدلیل نوآوریهای فراوانی که در روشهای جراحی انجام داد بهعنوان «پدر جراحی امروزی» میشناسند. زمانیکه جراح ارتش بود، روش درمان زخمها را با بستن شریانها به جای سوزاندن با اتوهای داغ یا روغن جوش معرفی کرد. پره همچنین پروتز را اختراع کرد که یک دست بود که با فنرها و قلابها برای یک کاپیتان ارتش فرانسه ساخت. او همچنین یک پروتز پا و پا با لولای زانویی اختراع کرد که دارای مهار قابل تنظیم، کنترل قفل زانو و سایر ویژگیهای مهندسیای بود که امروزه استفاده میشود. او جراح هنری دوم و سه جانشین او بود و کتابهایی در حوزههای آناتومی، جراحی، طاعون، زنان و زایمان و ناهنجاریها نوشت.

یولیوس ریشارد پتری
۲۰دسامبر ۱۹۲۱ میلادی برابر با 30 آذر ۱۳۰۰ خورشیدی، یولیوس ریشارد پتری، پزشک و باکتریشناس آلمانی درگذشت. او را بهدلیل نامی که به ظرف پتری دادهاند بهیاد میآورند. ظرف پتری، ظرفی کمعمق و استوانهای است که از پلاستیک یا شیشه با روکش ساخته شده و برای کشت بافت و نگهداری محیط جامد برای کشت و زیرکشت باکتریها استفاده میشود. پتری آن را برای تکنیک شبیهسازی سویههای باکتری با استفاده از شیب آگار و کشت فرعی در خود ظرف و شناسایی کلونیهای مختلف باکتری توسعه داد. او این ابزار آزمایشگاهی را زمانی اختراع کرد که بهعنوان دستیار رابرت کخ، باکتریشناس معروف آلمانی و کاشف عامل بیماری سل، کار میکرد.
انتهای پیام/
- تور استانبول
- غذای سازمانی
- خرید کارت پستال
- لوازم یدکی تویوتا قطعات تویوتا
- مشاوره حقوقی
- تبلیغات در گوگل
- بهترین کارگزاری بورس
- ثبت نام آمارکتس
- سایت رسمی خرید فالوور اینستاگرام همراه با تحویل سریع
- یخچال فریزر اسنوا
- گاوصندوق خانگی
- تاریخچه پلاک بیمه دات کام
- ملودی 98
- خرید سرور اختصاصی ایران
- بلیط قطار مشهد
- رزرو بلیط هواپیما
- ال بانک
- آهنگ جدید
- بهترین جراح بینی ترمیمی در تهران
- اهنگ جدید
- خرید قهوه
- اخبار بورس